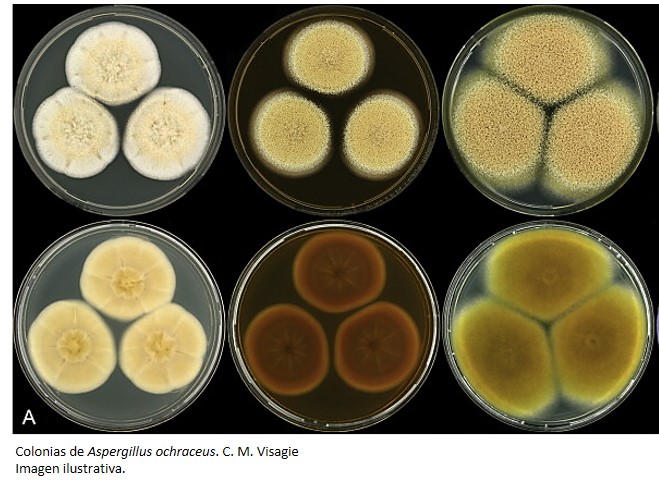

Primer reporte de Aspergillus ochraceus que ataca tubérculos de papa en Tayikistán
Usuario Martes, 14 de Octubre de 2025 Artículos Científicos
Se observaron papas con manchas oscuras y secas en la cáscara, dichas papa por dentro presentaban cavidades con micelio. Las observaciones culturales, morfológicas, la secuenciación de las regiones génicas y las pruebas de patogenicidad mostraron que la cepa aislada correspondía a Aspergillus ochraceus. Este es el primer reporte de A. ochraceus atacando tubérculos de papa.
- Más información en: link.springer.com
Noticias similares
-

Primer reporte de Pantoea agglomerans y Pseudomonas sp. causantes de marchitamiento de la fresa en Irán
En plantas de fresa se observó necrosis húmeda de rápida expansión en hojas y tallos. A los...
-

Primer reporte de Talaromyces pinophilus que causa roya de la soya en China
Se observaron manchas necróticas irregulares en soya. Entre el 50% y el 60% de las hojas...
-

Primer reporte mundial de Tobacco etch virus que ataca a la pitahaya en China
Se observaron plantas de Hylocereus undatus (pitahaya, fruta del dragón, etc.) con manchas...





